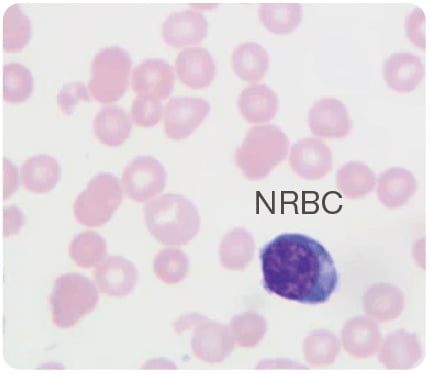

创新科技+人性化设计
完美融合

Flag报警及时响应异常,为临床决策保驾护

支持全血一管通,
实现血常规+CRP+SAA一次进样完成检测,
助力感染精准检测,防止抗生素滥用

自动复检功能智能筛选异常样本,
降低复检率,优化流程,降低综合使用成本。

实现体液检测自动化,减少手工误差
实现体液检测自动化,减少手工误差
 脑脊液中若检测到红细胞,见于各种原因引起的出血,如
脑脊液中若检测到红细胞,见于各种原因引起的出血,如 体液中白细胞计数以及白细胞分类,提示是否存在感染
体液中白细胞计数以及白细胞分类,提示是否存在感染


